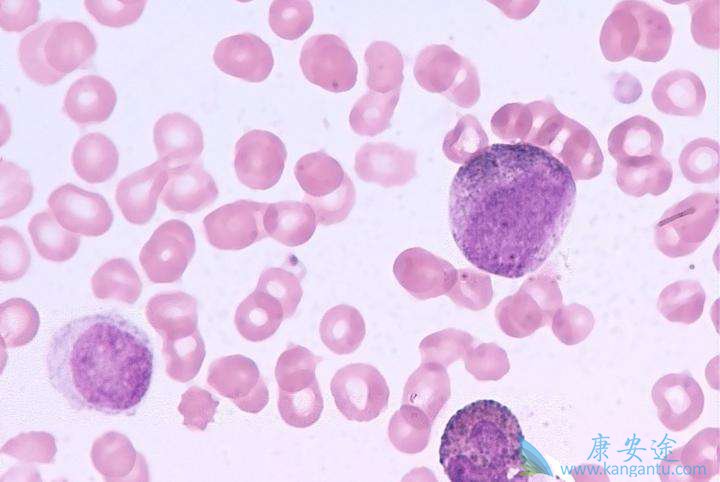
ܰϸ԰Ѫ

在总体人群中,与阿伐单抗相比,duvelisib的PI3K-δ和γ抑制剂的中位无进展生存期(PFS)为3.4个月。在17p缺失的患者中,PFS中位数中位数为3.7个月。
DUO研究员Ian Flinn博士,血液癌症研究计划主任博士,“尽管CLL / SLL的治疗近年来有所发展,但许多患者仍然有很大的未满足的需求,随着可用的治疗方法进展或复发,”莎拉·卡农研究所在一份声明中说。
“随机DUO研究的这些积极结果表明,duvelisib在具有复发性或难治性CLL / SLL的患者中包括可控的安全性特征,包括在17p缺失的高风险患者中延长PFS。对于我们的CLL / SLL患者,对于治疗这些患者的医生来说,在家中服用的方便的口服单一疗法将是治疗领域的有益补充。“Flinn补充说。
III期DUO研究将319例CLL / SLL患者以1:1的比例随机分为25 mg,每次两次,每次两次,直至疾病进展或不可接受的毒性,或第1天300mg的奥美单抗,随后每周7次输液和4次输液的2000毫克。
杜伐吡啶组的中位PFS为13.3个月,而阿托单抗组为9.9个月(风险比[HR],0.52;P <.0001)。在17p缺失的患者中,PFS中位数分别为12.7和9.0个月(HR,0.41; P = .0011)。
根据PI3K抑制剂制造商Verastem的说法,安全性数据符合血液恶性肿瘤单一剂量duvelisib的其他研究观察结果。该公司计划在未来的医疗会议上介绍DUO的完整结果,并将其出版数据提交给同行评议的期刊。
罗伯特·弗雷斯特(Robert Forrester)总裁罗伯特·弗雷斯特(Robert Forrester)总统说:“我们非常感谢参与DUO研究的患者,照顾者和调查人员,我们很高兴能够更加接近我们开展改善癌症患者生活的药物的使命。” Verastem首席执行官在一份声明中表示。
“我们与duvelisib单一疗法(DUO和DYNAMO)的晚期试验现在已经实现了其主要终点,突显了杜伐吡啶治疗晚期血液恶性肿瘤的重要潜力。Forrester补充说,我们预计将与FDA共同分析这些结果,准备在2018年上半年提交新的药物申请,并期待探讨其他癌症中duvelisib的后续发展机会。
在II期DYNAMO研究的以前发布的数据中,duvelisib对无痛非霍奇金淋巴瘤(iNHL)患者的总反应率(ORR)显示为46%。
本研究纳入129例iNHL患者,其中包括滤泡淋巴瘤(n = 83),SLL(n = 28)和边缘区淋巴瘤(n = 18)。这些组中的ORR分别为41%,68%和33%。中位反应时间为9.9个月。
2013年5月开始招收的开放标签II期DYNAMO研究包括iLHL患者对利妥昔单抗难治,化疗或放射免疫治疗。连续的杜伐吡啶以25mg每日两次施用。
在11.5个月的中位随访中,整个iNHL人群的中位生存期为18.4个月,平均PFS为8.4个月。
最常见的≥3级AE是中性粒细胞减少症(23%),贫血(12%),血小板减少症(10%)和腹泻(15%)。由于AE,17%的患者停止了duvelisib。有6例与AE相关的患者死亡。














请简单描述您的疾病情况,我们会有专业的医学博士免费为您解答问题(24小时内进行电话回访)